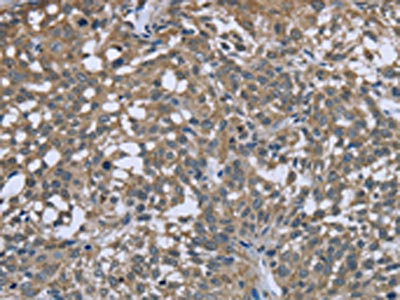

PTK2B Antibody
-
中文名稱:PTK2B兔多克隆抗體
-
貨號:CSB-PA914875
-
規格:¥1100
-
圖片:
-
The image on the left is immunohistochemistry of paraffin-embedded Human brain tissue using CSB-PA914875(PTK2B Antibody) at dilution 1/50, on the right is treated with fusion protein. (Original magnification: ×200)
-
The image on the left is immunohistochemistry of paraffin-embedded Human cervical cancer tissue using CSB-PA914875(PTK2B Antibody) at dilution 1/50, on the right is treated with fusion protein. (Original magnification: ×200)
-
Gel: 6%SDS-PAGE, Lysate: 40 μg, Lane: Raji cells, Primary antibody: CSB-PA914875(PTK2B Antibody) at dilution 1/300, Secondary antibody: Goat anti rabbit IgG at 1/8000 dilution, Exposure time: 1 minute
-
-
其他:
產品詳情
-
Uniprot No.:
-
基因名:
-
別名:CADTK antibody; CAK-beta antibody; CAKB antibody; CAKbeta antibody; Calcium regulated non receptor proline rich tyrosine kinase antibody; Calcium-dependent tyrosine kinase antibody; Cell adhesion kinase beta antibody; E430023O05Rik antibody; EC 2.7.10.2 antibody; FADK 2 antibody; FADK2 antibody; FAK2 antibody; FAK2_HUMAN antibody; Focal adhesion kinase 2 antibody; MGC124628 antibody; PKB antibody; Proline-rich tyrosine kinase 2 antibody; Protein kinase B antibody; Protein Tyrosine Kinase 2 Beta antibody; Protein-tyrosine kinase 2-beta antibody; PTK antibody; PTK2B antibody; PTK2B protein tyrosine kinase 2 beta antibody; PYK2 antibody; RAFTK antibody; RAFTK2 antibody; Related adhesion focal tyrosine kinase antibody
-
宿主:Rabbit
-
反應種屬:Human,Mouse,Rat
-
免疫原:Fusion protein of Human PTK2B
-
免疫原種屬:Homo sapiens (Human)
-
標記方式:Non-conjugated
-
抗體亞型:IgG
-
純化方式:Antigen affinity purification
-
濃度:It differs from different batches. Please contact us to confirm it.
-
保存緩沖液:-20°C, pH7.4 PBS, 0.05% NaN3, 40% Glycerol
-
產品提供形式:Liquid
-
應用范圍:ELISA,WB,IHC
-
推薦稀釋比:
Application Recommended Dilution ELISA 1:2000-1:5000 WB 1:500-1:2000 IHC 1:50-1:200 -
Protocols:
-
儲存條件:Upon receipt, store at -20°C or -80°C. Avoid repeated freeze.
-
貨期:Basically, we can dispatch the products out in 1-3 working days after receiving your orders. Delivery time maybe differs from different purchasing way or location, please kindly consult your local distributors for specific delivery time.
-
用途:For Research Use Only. Not for use in diagnostic or therapeutic procedures.
相關產品
靶點詳情
-
功能:Non-receptor protein-tyrosine kinase that regulates reorganization of the actin cytoskeleton, cell polarization, cell migration, adhesion, spreading and bone remodeling. Plays a role in the regulation of the humoral immune response, and is required for normal levels of marginal B-cells in the spleen and normal migration of splenic B-cells. Required for normal macrophage polarization and migration towards sites of inflammation. Regulates cytoskeleton rearrangement and cell spreading in T-cells, and contributes to the regulation of T-cell responses. Promotes osteoclastic bone resorption; this requires both PTK2B/PYK2 and SRC. May inhibit differentiation and activity of osteoprogenitor cells. Functions in signaling downstream of integrin and collagen receptors, immune receptors, G-protein coupled receptors (GPCR), cytokine, chemokine and growth factor receptors, and mediates responses to cellular stress. Forms multisubunit signaling complexes with SRC and SRC family members upon activation; this leads to the phosphorylation of additional tyrosine residues, creating binding sites for scaffold proteins, effectors and substrates. Regulates numerous signaling pathways. Promotes activation of phosphatidylinositol 3-kinase and of the AKT1 signaling cascade. Promotes activation of NOS3. Regulates production of the cellular messenger cGMP. Promotes activation of the MAP kinase signaling cascade, including activation of MAPK1/ERK2, MAPK3/ERK1 and MAPK8/JNK1. Promotes activation of Rho family GTPases, such as RHOA and RAC1. Recruits the ubiquitin ligase MDM2 to P53/TP53 in the nucleus, and thereby regulates P53/TP53 activity, P53/TP53 ubiquitination and proteasomal degradation. Acts as a scaffold, binding to both PDPK1 and SRC, thereby allowing SRC to phosphorylate PDPK1 at 'Tyr-9, 'Tyr-373', and 'Tyr-376'. Promotes phosphorylation of NMDA receptors by SRC family members, and thereby contributes to the regulation of NMDA receptor ion channel activity and intracellular Ca(2+) levels. May also regulate potassium ion transport by phosphorylation of potassium channel subunits. Phosphorylates SRC; this increases SRC kinase activity. Phosphorylates ASAP1, NPHP1, KCNA2 and SHC1. Promotes phosphorylation of ASAP2, RHOU and PXN; this requires both SRC and PTK2/PYK2.
-
基因功能參考文獻:
- LFA-1 cross-linking recruits and activates FAK1 and PYK2 to phosphorylate LAT selectively on a single Y-171 site that binds to the GRB2-SKAP1 complex and limits dwell times of T-cells with dendritic cells PMID: 28699640
- Pyk2 has a role in spine structure and synaptic function; its deficit contributes to Huntington's disease cognitive impairments PMID: 28555636
- Results provide evidence that Pyk2 phosphorylates STIM1 at its Y361 residue, activating thereby store-operated Ca(2+) entry. PMID: 28218251
- The authors' findings identify Pyk2 as a unique mediator of invadopodium formation and function and also provide a novel insight into the mechanisms by which Pyk2 mediates tumor cell invasion. PMID: 29133485
- Results show that VEGFA induces Pyk2 activation in mediating human retinal microvascular endothelial cell migration, sprouting and tube formation, and that Pyk2-mediated STAT3 activation is required for hypoxia-induced retinal neovascularization. PMID: 27210483
- Interestingly, rs2279590 locus has a widespread enhancer effect on two nearby genes, protein tyrosine kinase 2 beta (PTK2B) and epoxide hydrolase-2 (EPHX2); both of which have been previously associated with AD as risk factors. PMID: 28973302
- Multiple myeloma that is driven by deregulated iron homeostasis and/or Pyk2/beta-cateninn signaling is susceptible to deferasirox-induced apoptosis. PMID: 27602957
- In summary, our data suggested that PYK2 via S6K1 activation modulated AR function and growth properties in prostate cancer cells. Thus, PYK2 and S6K1 may potentially serve as therapeutic targets for PCa treatment. PMID: 27492635
- Our findings suggest that Pyk2 plays an important role in the coordination of stabilization of beta-catenin in the crosstalk between Wnt/beta-catenin and Wnt/Ca(2+) signaling pathways upon Wnt3a stimulation in differentiating hNPCs. PMID: 28694190
- STIM1-induced Ca(2+) signaling activates Pyk2 to inhibit the interaction of VE-PTP and VE-cadherin and hence increase endothelial permeability. PMID: 28385807
- Ascites and CCL18 stimulate the phosphorylation and expression of Pyk2, which positively regulates ascites-induced ovarian cancer cell migration. PMID: 27613122
- We demonstrated trophoblast cytoprotection by intervention with supraphysiological concentrations of relaxin, a process in part mediated through the PI3-kinase-Akt/PKB cell survival pathway. These results provide further rationale for clinical investigation of relaxin as a potential therapeutic in preeclampsia. PMID: 28122716
- PTK2B polymorphism (rs28834970) could modify the risk of late-onset Alzheimer's disease (LOAD), and PTK2B polymorphism (rs28834970) and APOE may interact to increase LOAD risk in a Han Chinese population. PMID: 27080426
- Studies suggest that PYK2 is a common downstream effector of ErbB and IL8 receptors, and that PYK2 integrates their signaling pathways through a positive feedback loop to potentiate breast cancer invasion. PMID: 26084289
- Pyk2 is a key downstream signaling molecules of CCR7 in SCCHN, which promotes SCCHN tumorigenesis and progression. PMID: 26352169
- Phosphoproteomic analysis identifies FAK2 as a potential therapeutic target for tamoxifen resistance in breast cancer. PMID: 26330541
- Pyk2-focal adhesion targeting domain interacts with and binds to leupaxin. PMID: 26866573
- Src has a role in priming Pyk2 (but not FAK) phosphorylation and subsequent activation downstream of integrins PMID: 26866924
- Data strongly suggest that chemokine-stimulated associations between Vav1, SLP-76, and ADAP facilitate Rac1 activation and alpha4beta1-mediated adhesion, whereas Pyk2 opposes this adhesion by limiting Rac1 activation. PMID: 26202465
- FAK and PYK2 functioned redundantly to promote the Wnt/beta-catenin pathway by phosphorylating GSK3beta(Y216) to reinforce pathway output-beta-catenin accumulation and intestinal tumorigenesis. PMID: 26274564
- This study identified Pyk2 as a cellular component required for the intracellular trafficking of HPV16 during infection. PMID: 26109718
- These results suggest that melatonin exerts anti-migratory and anti-invasive effects on glioma cells in response to hypoxia via reactive oxygen species-alphavbeta3 integrin-FAK/Pyk2 signaling pathways. PMID: 25889845
- data suggest a novel role for FAK in GPVI-dependent ROS formation and platelet activation and elucidate a proximal signaling role for FAK within the GPVI pathway. PMID: 25415317
- Orai1/Pyk2 pathway is essential for glioma migration and invasion. PMID: 25433371
- Pyk2-NDRG1 axis is possibly involved in conveying the anti-proliferative effect of beta-ionone in prostate cancer cells. PMID: 25219547
- Pyk2 has a role in integrin regulation of size and dynamics of signaling microclusters PMID: 25778396
- PYK2 is an intermediary component of Ca(2+) signaling between PKA-mediated and Tyr phosphorylations that is required for achieving functional human sperm capacitation. PMID: 25180269
- Data indicate that chicken paxillin leucine-aspartate LD2 and LD4 motifs preferentially dock at the helix 2/3 binding site of human Proline-rich tyrosine kinase 2 (Pyk2)-focal adhesion kinase (FAK). PMID: 25174335
- these data demonstrate that Pyk2 is a critical regulator of PI3K function downstream of the TCR. PMID: 25387834
- Data indicate the tumor-promoting role of proline-rich tyrosine kinase 2 (Pyk2) in multiple myeloma (MM), suggesting tyrosine kinase inhibitor as a therapeutic option in MM. PMID: 25217697
- inhibition of FAK, PYK2 and BCL-XL synergistically enhances apoptosis in ovarian clear cell carcinoma cell lines PMID: 24523919
- Pyk2 and Src are important in CCL18-induced breast cancer metastasis. PMID: 24142406
- High expression of proline-rich tyrosine kinase 2 is associated with hepatocellular carcinoma via regulating phosphatidylinositol 3-kinase/AKT pathway. PMID: 22618716
- Development of a coordinated allo T cell and auto B cell response against autosomal PTK2B after allogeneic hematopoietic stem cell transplantation. PMID: 24097630
- Pyk2 is essential for skin wound reepithelialization in vivo and in vitro and that it regulates epidermal keratinocyte migration via a pathway that requires PKCdelta and MMP functions. PMID: 24598361
- Pyk2 is a shared key mediator of targeted-therapy induced adhesion and migration; Targeting Pyk2 may serve as an effective therapeutic strategy to reduce extramedullar relpase in acute promyelocytic leukemia and chronic myeloid leukemia. PMID: 24176282
- We hypothesize a potential direct or indirect role for SRC, RAF1, PTK2B genes in neurotransmission and in central nervous system signaling processes. PMID: 24108181
- Determine a crucial role of LRP1-mediated Pyk2 phosphorylation on hypoxia-induced MMP-9 activation and hVSMC migration and therefore in hypoxia-induced vascular remodeling. PMID: 24072693
- Both Pyk2 and phosphorylated Pyk2[pY881] are potential prognostic factors and therapeutic targets for non-small-cell lung cancer. PMID: 23922106
- Our results confirm that RTKs are frequently altered in chordomas. PMID: 23618355
- Results indicate that in vitro Pyk2 might function to regulate cell adhesion and motility following all-trans-retinoic acid (ATRA). PMID: 23587524
- We conclude that the effects of selenoprotein H on mitochondrial biogenesis and mitochondrial function are probably mediated through protein kinase A-CREB-PGC-1alpha and Akt/protein kinase B-CREB-PGC-1alpha pathways. PMID: 23220172
- Data indicate protein secretion pathways activated by monosodium urate (MSU) in macrophages, and reveal a novel role for cathepsin B and Src, Pyk2, PI3 kinases in the activation of unconventional protein secretion. PMID: 23292187
- These results identify a novel pathway of integrin alphaIIbbeta3 outside-in signaling and recognize the tyrosine kinase Pyk2 as a major regulator of platelet adhesion and spreading on fibrinogen. PMID: 23216754
- the non-catalytic functions of the kinases Fyn and Pyk2 were required for late stage human T cell adhesion. PMID: 23300847
- SOCS3 definitely plays roles in regulating Pyk2 signaling and cell motility in A549 cells. PMID: 23302305
- PAC1 regulates PYK-2 tyrosine phosphorylation in a calcium-dependent manner in lung cancer cell lines. PMID: 22581436
- findings showed that Pyk2 is overexpressed in squamous cell carcinoma of the head and neck; data suggest that CCR7 via Pyk2 and cofilin regulates the chemotaxis and migration ability of metastatic squamous cell carcinoma of the head and neck cells PMID: 22923218
- Down-regulation of both miR-517a and miR-517c contribute to hepatocellular carcinoma cells development through regulating Pyk2. PMID: 23142219
- Pyk2, which was strongly activated by IGF-I, was critical for IGF-IR-dependent motility. PMID: 22859931
顯示更多
收起更多
-
相關疾病:Aberrant PTK2B/PYK2 expression may play a role in cancer cell proliferation, migration and invasion, in tumor formation and metastasis. Elevated PTK2B/PYK2 expression is seen in gliomas, hepatocellular carcinoma, lung cancer and breast cancer.
-
亞細胞定位:Cytoplasm. Cytoplasm, perinuclear region. Cell membrane; Peripheral membrane protein; Cytoplasmic side. Cell junction, focal adhesion. Cell projection, lamellipodium. Cytoplasm, cell cortex. Nucleus. Note=Interaction with NPHP1 induces the membrane-association of the kinase. Colocalizes with integrins at the cell periphery.
-
蛋白家族:Protein kinase superfamily, Tyr protein kinase family, FAK subfamily
-
組織特異性:Most abundant in the brain, with highest levels in amygdala and hippocampus. Low levels in kidney (at protein level). Also expressed in spleen and lymphocytes.
-
數據庫鏈接:
Most popular with customers
-
-
YWHAB Recombinant Monoclonal Antibody
Applications: ELISA, WB, IHC, IF, FC
Species Reactivity: Human, Mouse, Rat
-
-
-
-
-
-